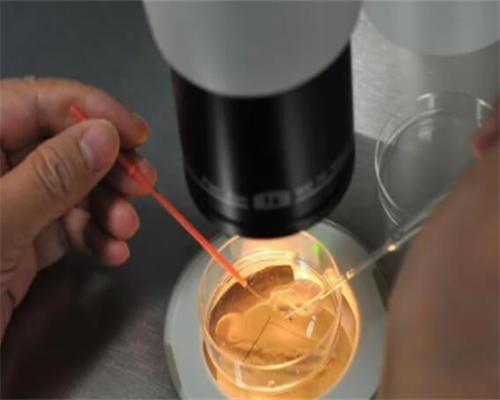
浙江捐卵仲介，浙江供卵试管服务，浙江试管婴儿多少钱一次

一、浙江供卵助孕公司
1、很难准确估计试管婴儿的成本。例如,在医疗费用方面,个人对药物的敏感性会导致不同的用药时间,导致不同的费用。其次,根据每个人的制度,有些人可能一次成功,但有些人可能一两次都不成功。虽然方法相同,但结果完全不同。一般来说,试管婴儿的费用一般包括三个方面:术前检查费用、试管婴儿药品费用、相关手术费用和实验室费用。浙江省人民医院试管婴儿费用有一个详细信息。让我们看一看,仅供参考。下面本文整理了有关内容,希望对大家有所帮助。
2、一般情况下,在试管婴儿治疗前,夫妻双方都要进行术前检查,主要是排除一些不适合试管婴儿的疾病,如传染病和不适合女性怀孕的疾病,费用在2000-3000元左右。
3、试管婴儿通过药物诱导排卵后取出女性的卵子,所以一般需要使用20-40种促排卵药物。此外,以前使用的降调节药总共需要9000-15000元。如果是进口的促排药,可能会比较贵。
4、取卵、培养、移植试管婴儿费用。
5、若有多余的好胚胎要冷冻保存,约10000元,而试管婴儿移植费用一般需要8000元左右,如单精子注射(ICSI)要加2000元。
6、此外,试管婴儿期间可能会消耗部分费用,即如果在试管婴儿手术前有影响手术的疾病,也需要先进行相关治疗。这部分费用因人而异。因此,建议想去浙江省人民医院做试管婴儿的患者可以根据自己的实际情况预约,以了解试管婴儿的费用,估计结果更准确。
7、浙江省妇保医院能做供卵三代试管,该医院早在2001年就开展了第三代试管婴儿技术,而且该医院也能供卵,所以只要符合要求,即女方要满足受卵适应症(如卵巢早衰、伴或不伴染色体畸变的卵巢发育异常、卵巢解剖位置异常导致的无法取卵等),女方或男方还要满足三代试管适应症(如患有遗传性疾病、复发性流产、不明原因反复种植失败等等),就可以在浙江省妇保医院申请做供卵三代试管。
8、浙江省妇保医院生殖中心目前能够开展夫精/供精人工授精,第一代、第二代以及第三代试管婴儿技术,该医院也能够做供精/供卵试管婴儿。因为该医院试管技术有三种,所以有供卵需求的患者可以根据自身情况来选择做几代供卵试管婴儿,而想要在浙江省妇保医院做三代供卵试管,就需要满足以下这些条件:
9、首先就是要满足受卵的适应症,可以分为两大类,一是无卵巢功能,丧失产生卵子的能力(如卵巢早衰;伴或不伴染色体畸变的卵巢发育异常;绝经前及绝经后要求再生育者等等),二是有卵巢功能(如女方是严重的遗传性疾病或基因携带者患者;有明显的影响卵子数量和质量的因素反复体外受精失败者;卵巢解剖位置异常,无法取卵);
10、其次就是要满足三代试管的适应症,如男方有染色体异常、性连锁疾病、单基因遗传病,因为是做供卵试管,所以女方不需要考虑这几点,不过若是女方在满足受卵条件下,之前有过复发性流产以及不明原因反复种植失败的情况,也可以做供卵三代试管;
二、浙江寻找捐卵女子
1、最后就是夫妻双方必须要具备真实有效的身份证、结婚证以及准生证这些证件。
2、虽然说,浙江省妇保医院能做供卵三代试管,但是只有满足以上这三个条件才可以在该医院申请做供卵三代试管,而且以上三个条件是缺一不可的。
3、注意孕期要保持良好的心情,饮食上要多吃一些富含蛋白质的食物,同时要多注意休息,吃好休息好,自然而然面色也就会更好。如果患者有其他疑问可以随时咨询优先顾问,优选试管顾问将为您提供最专业的的解答!
4、浙江是中国经济发达的省份,也是最受欢迎的试管婴儿助孕地之一。浙江助孕中介专业从事辅助生殖技术服务,为客户提供最优质的生殖保健管理服务。
5、浙江助孕中介为客户提供一站式服务,包括试管婴儿、辅助生殖技术、精子供体、卵源供体等,为客户提供完善的服务。浙江助孕中介试管婴儿助孕服务包括:
6、试管婴儿治疗:浙江助孕中介拥有最先进的设备和技术,能够进行先进的试管婴儿治疗,为客户提供最优质的服务。
7、卵源供体:浙江助孕中介拥有普遍的卵源供体,可以满足客户不同的需求。
8、精子供体:浙江助孕中介拥有最优质的精子供体,为客户提供最安全、有效的服务。
9、辅助生殖技术:浙江助孕中介拥有先进的设备和技术,能够提供最优质的辅助生殖技术服务。
10、浙江助孕中介为客户提供最优质的试管婴儿助孕服务,以下是浙江助孕医院排名:


